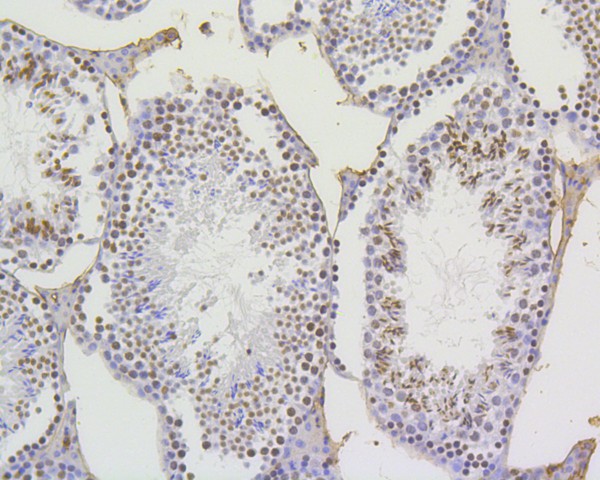
HA750050_9.jpg

Histone H4 (acetyl K5) Recombinant Rabbit Monoclonal Antibody [SR31-07]

cat.: HA750050
| Product Type: | Recombinant Rabbit monoclonal IgG, primary antibodies |
|---|---|
| Species reactivity: | Human, Mouse, Rat |
| Applications: | WB, IF-Cell, IF-Tissue, IHC-P, IP, ChIP, CUT&Tag-seq |
| Clonality: | Monoclonal |
| Clone number: | SR31-07 |
| Form: | Liquid |
| Storage condition: | Store at +4℃ after thawing. Aliquot store at -20℃ or -80℃. Avoid repeated freeze / thaw cycles. |
| Storage buffer: | 1*PBS (pH7.4). |
| Concentration: | 1ug/ul |
| Purification: | Protein A affinity purified. |
| Molecular weight: | Predicted band size: 11 kDa |
| Isotype: | IgG |
| Immunogen: | Synthetic peptide within Human Histone H4 aa 1-50 / 103 (acetyl K5). |
| Positive control: | HeLa cell lysate, NIH/3T3 cell lysate, NIH/3T3 treated with 400nM TSA for 18 hours cell lysate, C6 cell lysate, C6 treated with 1μM TSA for 18 hours cell lysate, HeLa, NIH/3T3, PC-12, human testis tissue, human colon tissue, human tonsil tissue, human colon carcinoma tissue, mouse testis tissue, mouse colon tissue, mouse brain tissue. |
| Subcellular location: | Nucleus, Chromosome. |
| Recommended Dilutions:
WB IF-Cell IF-Tissue IHC-P IP ChIP |
1:1,000-1:5,000 1:100-1:500 1:50-1:400 1:200-1:1,000 Use at an assay dependent concentration. Use 0.5~2 μg for 25 μg of chromatin. |
| Uniprot #: | SwissProt: P62805 Human | P62806 Mouse | P62804 Rat |
| Alternative names: | Histone gene cluster 1, H4A Histone gene cluster 2, H4 dJ160A22.1 dJ160A22.2 dJ221C16.1 dJ221C16.9 FO108 H4 H4 histone family, member A H4 histone family, member B H4 histone family, member C H4 histone family, member D H4 histone family, member E H4 histone family, member G H4 histone family, member H H4 histone family, member I H4 histone family, member J H4 histone family, member K H4 histone family, member M H4 histone family, member N H4 histone, family 2 H4/A H4/B H4/C H4/D H4/E H4/G H4/H H4/I H4/J H4/K H4/M H4/N H4/O H4/p H4_HUMAN H4F2 H4F2iii H4F2iv H4FA H4FB H4FC H4FD H4FE H4FG H4FH H4FI H4FJ H4FK HIST1 cluster, H4A HIST1 cluster, H4B HIST1 cluster, H4D HIST2H4 Hist4 cluster, H4 Hist4h4 histone 1, H4a histone 1, H4c histone 1, H4d histone 1, H4f histone 1, H4h histone 1, H4i histone 1, H4j histone 1, H4k histone 1, H4l histone 2, H4a histone 2, H4b ...... |
Images

|
Fig1:
Western blot analysis of Histone H4 (acetyl K5) on different lysates with Rabbit anti-Histone H4 (acetyl K5) antibody (HA750050) at 1/1,000 dilution. Lane 1: HeLa cell lysate Lane 2: NIH/3T3 cell lysate Lane 3: NIH/3T3 treated with 400nM TSA for 18 hours cell lysate Lane 4: C6 cell lysate Lane 5: C6 treated with 1μM TSA for 18 hours cell lysate Lysates/proteins at 10 µg/Lane. Predicted band size: 11 kDa Observed band size: 11 kDa Exposure time: 8 seconds; ECL: K1801; 4-20% SDS-PAGE gel. Proteins were transferred to a PVDF membrane and blocked with 5% NFDM/TBST for 1 hour at room temperature. The primary antibody (HA750050) at 1/1,000 dilution was used in 5% NFDM/TBST at 4℃ overnight. Goat Anti-Rabbit IgG - HRP Secondary Antibody (HA1001) at 1/50,000 dilution was used for 1 hour at room temperature. |

|
Fig2:
Immunocytochemistry analysis of HeLa cells labeling Histone H4 (acetyl K5) with Rabbit anti-Histone H4 (acetyl K5) antibody (HA750050) at 1/500 dilution. Cells were fixed in 4% paraformaldehyde for 15 minutes at room temperature, permeabilized with 0.1% Triton X-100 in PBS for 15 minutes at room temperature, then blocked with 1% BSA in 10% negative goat serum for 1 hour at room temperature. Cells were then incubated with Rabbit anti-Histone H4 (acetyl K5) antibody (HA750050) at 1/500 dilution in 1% BSA in PBST overnight at 4 ℃. Goat Anti-Rabbit IgG H&L (iFluor™ 488, HA1121) was used as the secondary antibody at 1/1,000 dilution. PBS instead of the primary antibody was used as the secondary antibody only control. Nuclear DNA was labelled in blue with DAPI. Beta tubulin (HA601187, red) was stained at 1/100 dilution overnight at +4℃. Goat Anti-Mouse IgG H&L (iFluor™ 594, HA1126) was used as the secondary antibody at 1/1,000 dilution. |

|
Fig3:
Immunocytochemistry analysis of NIH/3T3 cells labeling Histone H4 (acetyl K5) with Rabbit anti-Histone H4 (acetyl K5) antibody (HA750050) at 1/500 dilution. Cells were fixed in 4% paraformaldehyde for 15 minutes at room temperature, permeabilized with 0.1% Triton X-100 in PBS for 15 minutes at room temperature, then blocked with 1% BSA in 10% negative goat serum for 1 hour at room temperature. Cells were then incubated with Rabbit anti-Histone H4 (acetyl K5) antibody (HA750050) at 1/500 dilution in 1% BSA in PBST overnight at 4 ℃. Goat Anti-Rabbit IgG H&L (iFluor™ 488, HA1121) was used as the secondary antibody at 1/1,000 dilution. PBS instead of the primary antibody was used as the secondary antibody only control. Nuclear DNA was labelled in blue with DAPI. Beta tubulin (HA601187, red) was stained at 1/100 dilution overnight at +4℃. Goat Anti-Mouse IgG H&L (iFluor™ 594, HA1126) was used as the secondary antibody at 1/1,000 dilution. |

|
Fig4:
Immunocytochemistry analysis of PC-12 cells labeling Histone H4 (acetyl K5) with Rabbit anti-Histone H4 (acetyl K5) antibody (HA750050) at 1/100 dilution. Cells were fixed in 4% paraformaldehyde for 15 minutes at room temperature, permeabilized with 0.1% Triton X-100 in PBS for 15 minutes at room temperature, then blocked with 1% BSA in 10% negative goat serum for 1 hour at room temperature. Cells were then incubated with Rabbit anti-Histone H4 (acetyl K5) antibody (HA750050) at 1/100 dilution in 1% BSA in PBST overnight at 4 ℃. Goat Anti-Rabbit IgG H&L (iFluor™ 488, HA1121) was used as the secondary antibody at 1/1,000 dilution. PBS instead of the primary antibody was used as the secondary antibody only control. Nuclear DNA was labelled in blue with DAPI. Beta tubulin (HA601187, red) was stained at 1/100 dilution overnight at +4℃. Goat Anti-Mouse IgG H&L (iFluor™ 594, HA1126) was used as the secondary antibody at 1/1,000 dilution. |

|
Fig5:
Immunohistochemical analysis of paraffin-embedded human testis tissue with Rabbit anti-Histone H4 (acetyl K5) antibody (HA750050) at 1/1,000 dilution. The section was pre-treated using heat mediated antigen retrieval with sodium citrate buffer (pH 6.0) (high pressure) for 2 minutes. The tissues were blocked in 1% BSA for 20 minutes at room temperature, washed with ddH2O and PBS, and then probed with the primary antibody (HA750050) at 1/1,000 dilution for 1 hour at room temperature. The detection was performed using an HRP conjugated compact polymer system. DAB was used as the chromogen. Tissues were counterstained with hematoxylin and mounted with DPX. |

|
Fig6:
Immunohistochemical analysis of paraffin-embedded human colon tissue with Rabbit anti-Histone H4 (acetyl K5) antibody (HA750050) at 1/1,000 dilution. The section was pre-treated using heat mediated antigen retrieval with sodium citrate buffer (pH 6.0) (high pressure) for 2 minutes. The tissues were blocked in 1% BSA for 20 minutes at room temperature, washed with ddH2O and PBS, and then probed with the primary antibody (HA750050) at 1/1,000 dilution for 1 hour at room temperature. The detection was performed using an HRP conjugated compact polymer system. DAB was used as the chromogen. Tissues were counterstained with hematoxylin and mounted with DPX. |

|
Fig7: Immunohistochemical analysis of paraffin-embedded human tonsil tissue using anti-Histone H4 (acetyl K5) antibody. The section was pre-treated using heat mediated antigen retrieval with Tris-EDTA buffer (pH 9.0) for 20 minutes.The tissues were blocked in 5% BSA for 30 minutes at room temperature, washed with ddH2O and PBS, and then probed with the primary antibody (HA750050, 1/1,000) for 30 minutes at room temperature. The detection was performed using an HRP conjugated compact polymer system. DAB was used as the chromogen. Tissues were counterstained with hematoxylin and mounted with DPX. |

|
Fig8: Immunohistochemical analysis of paraffin-embedded human colon carcinoma tissue using anti-Histone H4 (acetyl K5) antibody. The section was pre-treated using heat mediated antigen retrieval with Tris-EDTA buffer (pH 9.0) for 20 minutes.The tissues were blocked in 5% BSA for 30 minutes at room temperature, washed with ddH2O and PBS, and then probed with the primary antibody (HA750050, 1/200) for 30 minutes at room temperature. The detection was performed using an HRP conjugated compact polymer system. DAB was used as the chromogen. Tissues were counterstained with hematoxylin and mounted with DPX. |
|
Fig9: Immunohistochemical analysis of paraffin-embedded mouse testis tissue using anti-Histone H4 (acetyl K5) antibody. The section was pre-treated using heat mediated antigen retrieval with Tris-EDTA buffer (pH 9.0) for 20 minutes.The tissues were blocked in 5% BSA for 30 minutes at room temperature, washed with ddH2O and PBS, and then probed with the primary antibody (HA750050, 1/1,000) for 30 minutes at room temperature. The detection was performed using an HRP conjugated compact polymer system. DAB was used as the chromogen. Tissues were counterstained with hematoxylin and mounted with DPX. |

|
Fig10: Immunofluorescence staining of paraffin- embedded rat brain tissue using anti-Histone H4(acetyl K5) antibody.The section was pre-treated using heat mediated antigen retrieval with Tris-EDTA buffer (pH 9.0) for 20 minutes. The tissues were blocked in 10% negative goat serum for 1 hour at room temperature, washed with PBS, and then probed with HA750050 at 1/300 dilution for 10 hours at 4℃ and detected using Alexa Fluor® 488 conjugate-Goat anti-Rabbit IgG (H+L) Secondary Antibody at a dilution of 1:500 for 1 hour at room temperature. |

|
Fig11: Chromatin immunoprecipitations were performed with cross-linked chromatin from HeLa cells with Histone H4 (acetyl K5) (HA750050) or Normal Rabbit IgG according to the ChIP protocol. The enriched DNA was quantified by real-time PCR using indicated primers. The amount of immunoprecipitated DNA in each sample is represented as signal relative to the total amount of input chromatin, which is equivalent to one. |
Note: All products are “FOR RESEARCH USE ONLY AND ARE NOT INTENDED FOR DIAGNOSTIC OR THERAPEUTIC USE”.